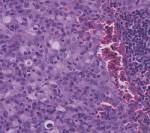

May 2020 - Presented by Raymond Gong (Mentored by Regina Gandour-Edwards)
Clinical History
The patient is a 50-year-old male who presented with facial swelling near the region of the right parotid gland for several months. The patient was asymptomatic except for a rapid increase in size of the swelling. Physical examination was notable only for an enlarged right parotid tail containing an indurated mass immediately adjacent to the retromandibular region. A computed tomography (CT) scan demonstrated two adjacent masses with mildly ill-defined margins about the inferior aspect of the right parotid gland measuring 3.2 cm and 1.6 cm in greatest diameters.
A referral to Otolaryngology was made to discuss treatment options. The patient elected for excision of the tumor and underwent a right superficial parotidectomy. Intraoperatively, moderate adherence of tumor to surrounding tissue was noted. A frozen section procedure was performed on the resected parotid mass and revealed the presence of a high-grade malignancy with lymph node involvement.
Gross Description
The resection specimen consisted of a 5.5 x 3.9 x 2.5 cm lobular mass with patchy adherent tan-yellow fibroadipose tissue over the external surface. Cut surfaces showed an encapsulated tan-gray tumor without hemorrhage or necrosis located 0.1 cm from the closest surgical margin.
Microscopic Description
Sections of the mass demonstrated nests and cords of large pleomorphic cells with vesicular nuclei, prominent nucleoli, moderate amounts of eosinophilic cytoplasm, and indistinct cell borders. A prominent lymphoid infiltrate, composed of small mature-appearing lymphocytes with follicle and germinal center formation, was present in and around the aggregates of large pleomorphic cells (Figures 1 and 2). Mitotic figures were readily identifiable (Figure 3). Immunohistochemical staining for AE1/AE3 was positive in the large pleomorphic cells (Figure 4). Synaptophysin and p40 were negative while CD45 was positive only in the lymphoid infiltrate (Figure 5). Epstein-Barr virus-encoded RNA by in situ hybridization (EBER ISH) was negative.
Figure 1: Low magnification view of the tumor’s solid growth pattern with a prominent admixed lymphoid infiltrate (5x)
Figure 2: The associated lymphoid infiltrate was dense, composed primarily of small mature-appearing lymphocytes, and formed follicles with germinal centers (40x)
Figure 3: High magnification view of the large pleomorphic tumor cells, including a mitotic figure at the center of the field (400x)
Figure 4: Cytokeratin cocktail AE1/AE3 was positive in the large pleomorphic cells (5x)
Figure 5: Hematopoietic lineage marker CD45 was positive in the lymphoid infiltrate and negative in the large pleomorphic cells (5x)

Meet our Residency Program Director
